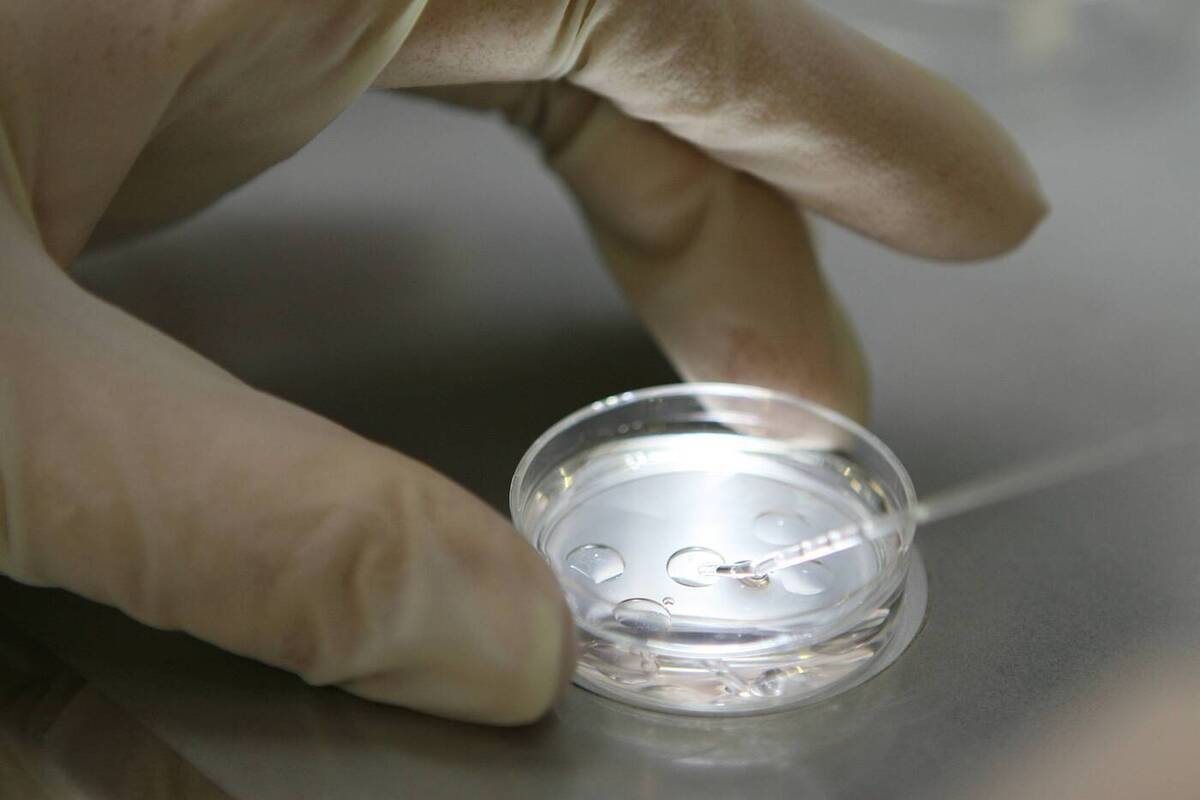
As the years go by, the human brain expands in some places: scientists find

Nobel laureate James Watson, who described DNA, has died in the US.

DNA pioneer James Watson has died in the United States at the age of 98.

test banner under the title image
Nobel laureate and co-discoverer of the structure of DNA, James Watson, has died in the United States at the age of 97, the Associated Press reports.
The scientist's son shared some details about Watson's final months. He said his father was in a hospice in New York City, where he was being treated for an infectious disease.
Unfortunately, the medical team's efforts yielded no positive results, and the distinguished scientist died. In 1953, Watson, along with his colleague Francis Crick, discovered and described the structure of DNA. This paved the way for the development of molecular biology and genetics for decades to come.
The results of Watson-Crick's research are still used today, including in modern medicine and bioengineering. A few years after their fundamental discovery, in 1962, the scientists were awarded the Nobel Prize in Medicine or Physiology.
MK previously reported that TV presenter and actor Yuri Nikolaev died at the age of 76.
Your reliable news feed - MK in MAX .
mk.ru